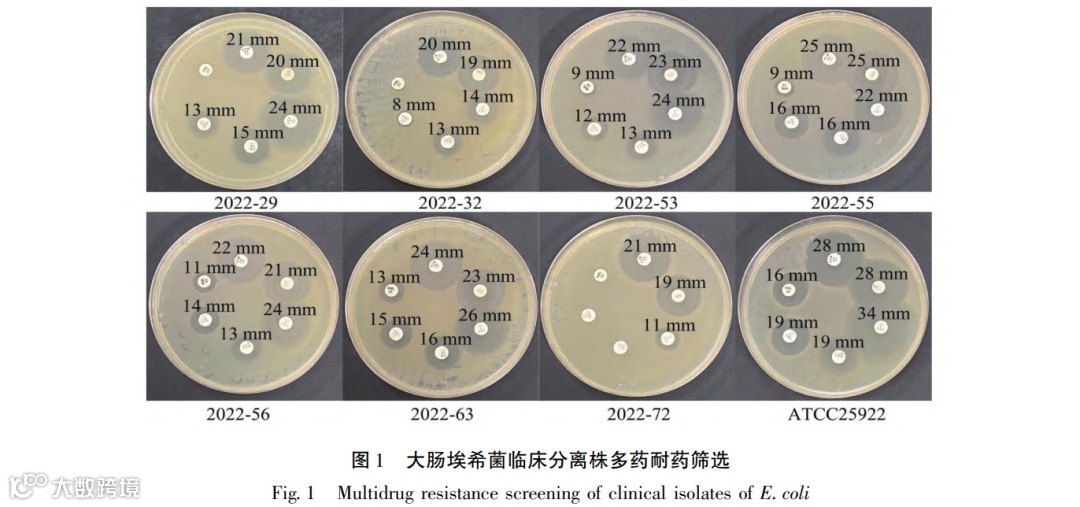
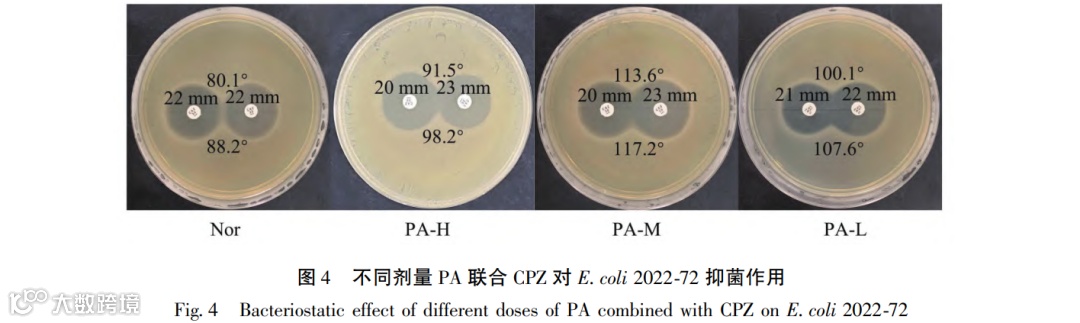

成都中医药大学药学院 西南特色中药资源国家重点实验室


超广谱β-内酰胺酶(extended spectrum β-lactamases,ESBLs)是主要由携带ESBLs基因的肠杆菌科几种革兰氏阴性菌分泌的水解酶,可高效水解β-内酰胺环使广谱头孢菌素(包括第三代和第四代)和单环类(氨曲南)等抗菌药物失活。目前流行病学调查研究显示,产ESBLs肠杆菌特别是大肠埃希菌引起的感染已成为21世纪全球面临的最大健康威胁之一。长期以来,碳青霉烯类抗生素一直是治疗产ESBLs细菌诱导感染的首选药。由于抗生素的过度或不规范使用,细菌通过基因突变或质粒水平传递等多种途径,已经出现耐碳青霉烯类大肠埃希菌。据中国细菌耐药检测网(www.carss.cn)数据统计信息,2022年大肠埃希菌对第三代头孢菌素耐药率全国平均为48.6%,对碳青霉烯类药物的耐药率全国平均为1.5%,最高地区可达到2.8%。在过去的几十年里,没有新种类的抗生素或替代品得到临床批准。继续进行新的抗菌化合物开发,研究周期和投资都是巨大的负担。应对耐药菌引发的感染、降低致死率以及高昂治疗费带来的经济压力是临床迫切需要解决的问题和挑战。
中西药联合使用可以提高疗效、减轻临床症状,已成为抗复杂细菌感染治疗的临床常用策略。项目组前期研究成果显示中药或提取物单用虽然只能发挥温和的抗菌作用,但是当与抗生素联合以后,不但可以提高抗生素的抗菌效果,还可大大降低药物使用量。这与相关研究报道相一致。结合中药的优势和特色,利用抗菌药与中药有效成分组合,提高药物疗效是一很有前途的药物研发思路,不仅可以缩短开发时间且更具临床安全性优势。项目组在前期中药抗菌有效成分筛选及效价评价研究中发现,黄柏、黄连、黄芩、三棵针和南天竹等清热解毒药中的重要异喹啉类生物碱巴马汀(palmatine,PA)具有很好的抗产ESBLs菌增效潜力。基于此,本研究拟进一步探讨PA与头孢哌酮(cefoperazone,CPZ)联合使用对产ESBLs大肠埃希菌的抗菌增效强度及可能机制,为临床治疗由产ESBLs大肠埃希菌引起的感染提供了新的策略和理论依据。

产ESBLs大肠埃希菌的临床耐药日益严峻,对患者的健康安全已构成直接威胁。目前报道,产ESBLs大肠埃希菌基因型主要包括SHV、CTX-M和TEM型。在我国,CTX-M型β-内酰胺酶是最为常见。通过K-B法及PCR技术分离得到一株CTX-M型多药耐药大肠埃希菌(E. coli 2022-72),DDSM法和FIC指数测定,证实PA联用CPZ具有抗菌增效作用。在此菌株上,PA(150μmol/L)可使CPZ抑菌圈直径提高3mm,抑菌环交界角度大于90°,表明有显著的协同作用。联用后CPZ MIC由32μg/mL降至8μg/mL,PA MIC由256μg/mL降至32μg/mL,FIC指数为0.375,低于0.5,也表明两药联用发挥抗菌协同作用。
药物的抗菌协同增效作用通常与以下机制相关:抑制细菌产生的水解酶活性,破坏细菌的水解酶和生物膜,以及通过干扰细菌代谢途径。我们选用分子对接技术预测PA与CTX-M型ESBLs的结合能力,结果显示两者结合能为-7.2kcal/mol,PA与蛋白活性结构域中氨基酸残基Ser237、Asn132、Asn170存在氢键作用。因此进一步开展了PA抑ESBLs活性试验,结果表明随着PA浓度增加,体系变色时间延长,且呈现剂量依赖性。同时三相水解实验表明PA不能改变抑菌环的“缺口”。以上实验结果表明,PA虽对酶无直接灭活作用,但能通过抑制ESBLs活性从而表现出增效作用。
大鼠细菌(E. coli 2022-72)感染性肺炎模型评估PA与CPZ联合用药的体内抗感染保护作用。结果显示,Mod组大鼠体重下降显著,而PA+CPZ组体重回升,但未超过造模前水平。肺泡灌洗液细菌计数显示,PA+CPZ组抑菌效果最佳,几乎无活菌。Mod组左肺脏器系数(0.1458±0.025)相较于Nor组(0.1110±0.008)增大,PA+CPZ组脏器系数为0.1301±0.028,有明显的水肿改善。肺组织病理学检测结果进一步证实,PA+CPZ组在抑制炎症反应方面表现最佳,仅局部区域观察到少量炎性细胞浸润,血清中IL-6和TNF-α含量具极显著降低(P<0.01),CRP含量也有显著性降低(P<0.05)。以上结果均表明,PA与CPZ联用不仅表现在抗菌作用的协同增效,也表现为抗炎作用的协同增效。
药物动力学(pharmacokinetics,PK)可能是影响药物协同增效的关键影响因素。因此,对二者联合应用是否影响动力学参数,我们对CPZ和PA单药及联合用药在大鼠体内的PK参数进行了系统性评估。结果显示,联合用药中两药PK参数与两药单用PK参数无显著变化,因此,两药的协同增效作用并不是基于动力学的相互作用。
相关研究显示,4μg/mL的vaborbactam可以将A类产ESBLs的菌株(KPC-2/KPC-3、SME和NMC-A)的美罗培南MIC由0.125~16μg/mL降低至0.03μg/mL。Karlowsky等探究relebactam联合亚胺培南对772株产ESBLs肠杆菌的抗菌作用,结果显示联用后亚胺培南对受试菌株MIC为0.03~32μg/mL,MIC50为0.12μg/mL,相较于单用亚胺培南(MIC为0.5~32μg/mL,MIC50为0.5μg/mL)具有一定的提升。Zhou等对Sophorea alopecuroides L.提取的总生物碱进行体外活性实验发现,添加6~10mg/mL的总生物碱会显著增加产ESBLs菌对头孢噻肟和头孢他啶的敏感性,与单独使用头孢噻肟与头孢他啶相比,联用后头孢噻肟和头孢他啶的MIC降低了8~16倍。本研究发现32μg/mLPA可使CPZ MIC由32μg/mL降至8μg/mL,在增效强度方面优于vaborbactam、relebactam和S. alopecuroides总生物碱等物质。Vaborbactam是一种环状硼酸类β-内酰胺酶抑制剂,其硼酸基团能与β-内酰胺酶的丝氨酸残基形成共价键。Relebactam则属于二氮杂双环辛烷类β-内酰胺酶抑制剂。PA是一种异喹啉类生物碱,其结构与前两者不同,缺乏硼酸和二氮杂双环辛烷结构,但三者均含有氮原子和多元杂环结构。
除此之外,多项研究提示单味中药及中药复方具有抑制ESBLs的巨大潜力。Lu发现三黄汤、黄连解毒汤和五味消毒饮可抑制ESBLs的活性和表达,3种复方汤剂在质量浓度均为1.0g/mL的浓度下对ESBLs活性抑制率分别为43.9%、58.5%和76.3%。Cao等发现芦荟大黄素、木犀草素、苦参碱、黄连素和香紫苏醇等中药成分对ESBLs活性的抑制作用,其中抑酶效果最好的是芦荟大黄素,90μg/mL时,其抑酶率为81.7%;其次为苦参碱,其抑酶率为71.7%。清开灵与头孢哌酮-舒巴坦钠联用能显著降低后者的最小抑菌浓度至原来的25%,双黄连与头孢哌酮-舒巴坦钠联用能将MIC降低50%。
本研究中的PA是常用清热解毒药中重要的生物碱成分,其与抗生素联合使用,不但可以通过抑制ESBLs活性提高耐药菌对抗生素的敏感性,同时兼具体内的抗炎作用,是一极具开发价值的中药抗菌增效剂。将PA与抗菌药物组合研发兼具安全性和有效性的新型抗菌药物,药物的用药成本低,相对于新型抗菌药物的研发更具发展前景。该研究成果发表在《天然产物研究与开发》2025年第11期,欢迎引用(点击左下方“阅读原文”可查看全文)。
 引用格式:王 辉,梁 迪,赵元静,等.巴马汀与头孢哌酮联用对产超广谱β-内酰胺酶大肠埃希菌的抗菌协同作用研究[J].天然产物研究与开发,2025,37:2090-2101. Wang H,Liang D,Zhao YJ,et al.Synergistic antimicrobial effect of palmatine in combination with cefoperazone against extended spectrum β-lactamases producing Escherichia coli[J].Nat Prod Res Dev,2025,37:2090-2101.
引用格式:王 辉,梁 迪,赵元静,等.巴马汀与头孢哌酮联用对产超广谱β-内酰胺酶大肠埃希菌的抗菌协同作用研究[J].天然产物研究与开发,2025,37:2090-2101. Wang H,Liang D,Zhao YJ,et al.Synergistic antimicrobial effect of palmatine in combination with cefoperazone against extended spectrum β-lactamases producing Escherichia coli[J].Nat Prod Res Dev,2025,37:2090-2101.


 点击阅读原文可查看全文
点击阅读原文可查看全文


